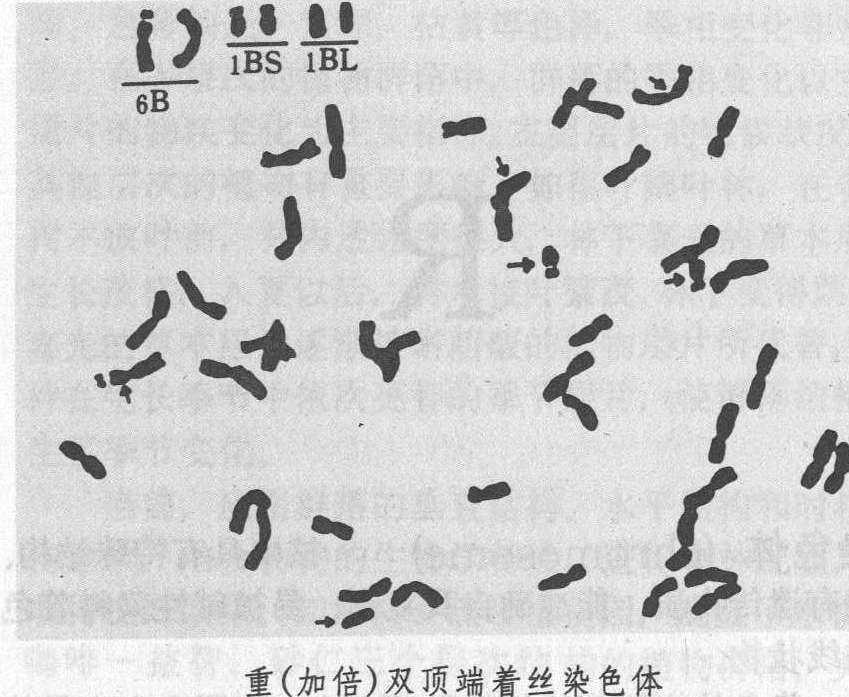

| 释义 |
染色体非整倍性chromosome aneuploidy个别染色体增减并非染色体组数增减的现象。正常二倍体个体称双体或二体(2n)。增加1条染色体为2n+1,称三体; 减少一条为2n-1,称单体; 2n-2为缺体;2n+2为四体;2n+1+1为双三体等等。 类别 单体 2n体细胞的某同源染色体只有一个而不是两个的现象,即2n-1。大多数动植物的单体不能存活,只有多倍体的小麦和烟草分别有成套的21种和24种不同的单体,是细胞遗传学研究、进行基因定位的基础材料。单体减数分裂可以形成n和n-1配子。根据正常双体小麦与单体的正反交测定,得知n和n-1的雌雄配子的传递率不同,n-1卵细胞的传递率为61~86%,平均为75%,n卵细胞的传递率为25%,而n-1雄配子的传递率为1~19%,平均为4%,n雄配子为96%。据此,单体自交后代的染色体数目分别为双体(2n)的24%,单体(2n-1)73 %,缺体(2n-2)3%。由此可知,必需逐代进行细胞学鉴定,才能保存单体植株。双单体是2n细胞中两对同源染色体各减少一条染色体,即2n-1-1。 三体 2n体细胞的某同源染色体为三个的现象,即2n+1。最初在蔓陀罗中发现三体,其12种三体(n=12)就有12种蒴果形状表型。三体有三种:❶初级三体为2n+1,减数分裂前期I配对时形成(n-1)Ⅱ+Ⅲ(Ⅱ表示二价体,Ⅲ表示三价体); ❷次级三体,增加的一条染色体为等臂染色体,每一个初级三体有相应的两个次级三体的可能; ❸三级三体,增加的一条染色体由两条不同源的染色体片段组成。此外,双三体是2n细胞中两对同源染色体各增加一条染色体。 四体 2n体细胞的一对同源染色体增加2条染色体的现象,即2n+2,可通过三体自交产生。四体减数分裂后期I四条染色体的分离有2:2、3:1、4:0,甚至还有0:0等可能的形式。从理论上讲四体可以大量形成2n+1配子,但实际上从2n与(2n+2)的杂交后代中2n+1的个体只有40~50%。四体自交可以得到2n+1、2n个体,但2n+2的个体却很少。 缺体 二体生物的体细胞缺失了某一对同源染色体的现象,即2n-2。由于缺掉一对染色体,个体的生存和生长都受到很大影响,缺体最早在燕麦中发现,普通小麦等少数物种有人工保存的成套缺体。缺体的不良影响比单体大,许多性状和双体有明显的变化,而单体与双体在外表上则差异不大。 单顶端着丝点单体 这种个体不仅缺失一条完整的染色体,另一条染色体也缺掉一臂,只留下带有顶端着丝点的染色体,即2n-1 1/2。在减数分裂时可形成n-1和n-1/2的配子。 双顶端着丝点染色体 这种个体中的一条染色体着丝点断裂,形成两条各带着丝点的染色体。 重(加倍)双顶端着丝点染色体 这种个体的两条同源染色体着丝点断裂,形成两对端着丝点的染色体,即20″+t″ +t″(见图)在普通小麦中这种重双顶端着丝点染色体已成套。在减数分裂时配对和分离都正常。 等臂染色单体 单体的单价染色体是由顶端着丝点染色体形成的等臂染色体,在减数分裂时,形成20″和一个等臂染色体,等臂染色体在后期Ⅰ可能进入细胞一极或被排除。 双等臂染色体 染色体总数为2n,但其中有一对为同源的等臂染色体,所以实际上既是缺失,又是重复,这种个体染色体配对和分离正常。
单体+顶端着丝点染色体 这种植株的染色体数目正常,但与正常2n的染色体组成不同,它有(n-1)个二价体,1个单价体和1个顶端着丝点染色体。如果这个顶端着丝点染色体与这个单价体同源,则在减数分裂前期Ⅰ时同源部分进行配对,如果不同源则不能配对。 单体+等臂染色体 这种植株体细胞里染色体数为2n,但其中有一条等臂染色体,即20Ⅱ +Ⅰ+等臂染色体,通常这条等臂染色体不同这条单价体配对,但假如它与单价体的臂同源时则可配对。 成因 非整倍体个体产生的主要原因是在生殖母细胞减数分裂过程中,或在受精卵的卵裂过程中,染色体复制和分配不正常所致。主要由减数分裂后期Ⅰ某一对同源染色体不离开,或后期Ⅱ某一染色体的两个染色单体不离开引起的。如果不离开发生在配子形成过程中,那么就形成n+1和n-1两类异常配子。当这些配子与正常配子(n)结合,就发育为单体性(2n-1)或三体性(2n+1)个体。如果不离开发生在受精卵以后的胚胎发育早期中,那么单体性和三体性的体细胞就可以在同一个体中同时存在,而形成嵌合体或混倍体。 意义 非整倍体一般繁殖力和生活力都比较差,在商业上和农用品种中没有直接应用价值,但是在遗传学研究上,是进行非整倍体分析和基因定位的基础材料(见基因定位)。通过这种方法确定某个基因在哪条染色体上,或是哪条染色体上带有哪些基因。非整倍体分析包括单体分析、三体分析和缺体分析三种。由于在二倍体植物中,单体和缺体不能成活或不存在,所以单体分析和缺体分析用于小麦、燕麦、烟草等多倍体植物,而二倍体植物如水稻、大麦、玉米和番茄等植物则采用三体分析。 |